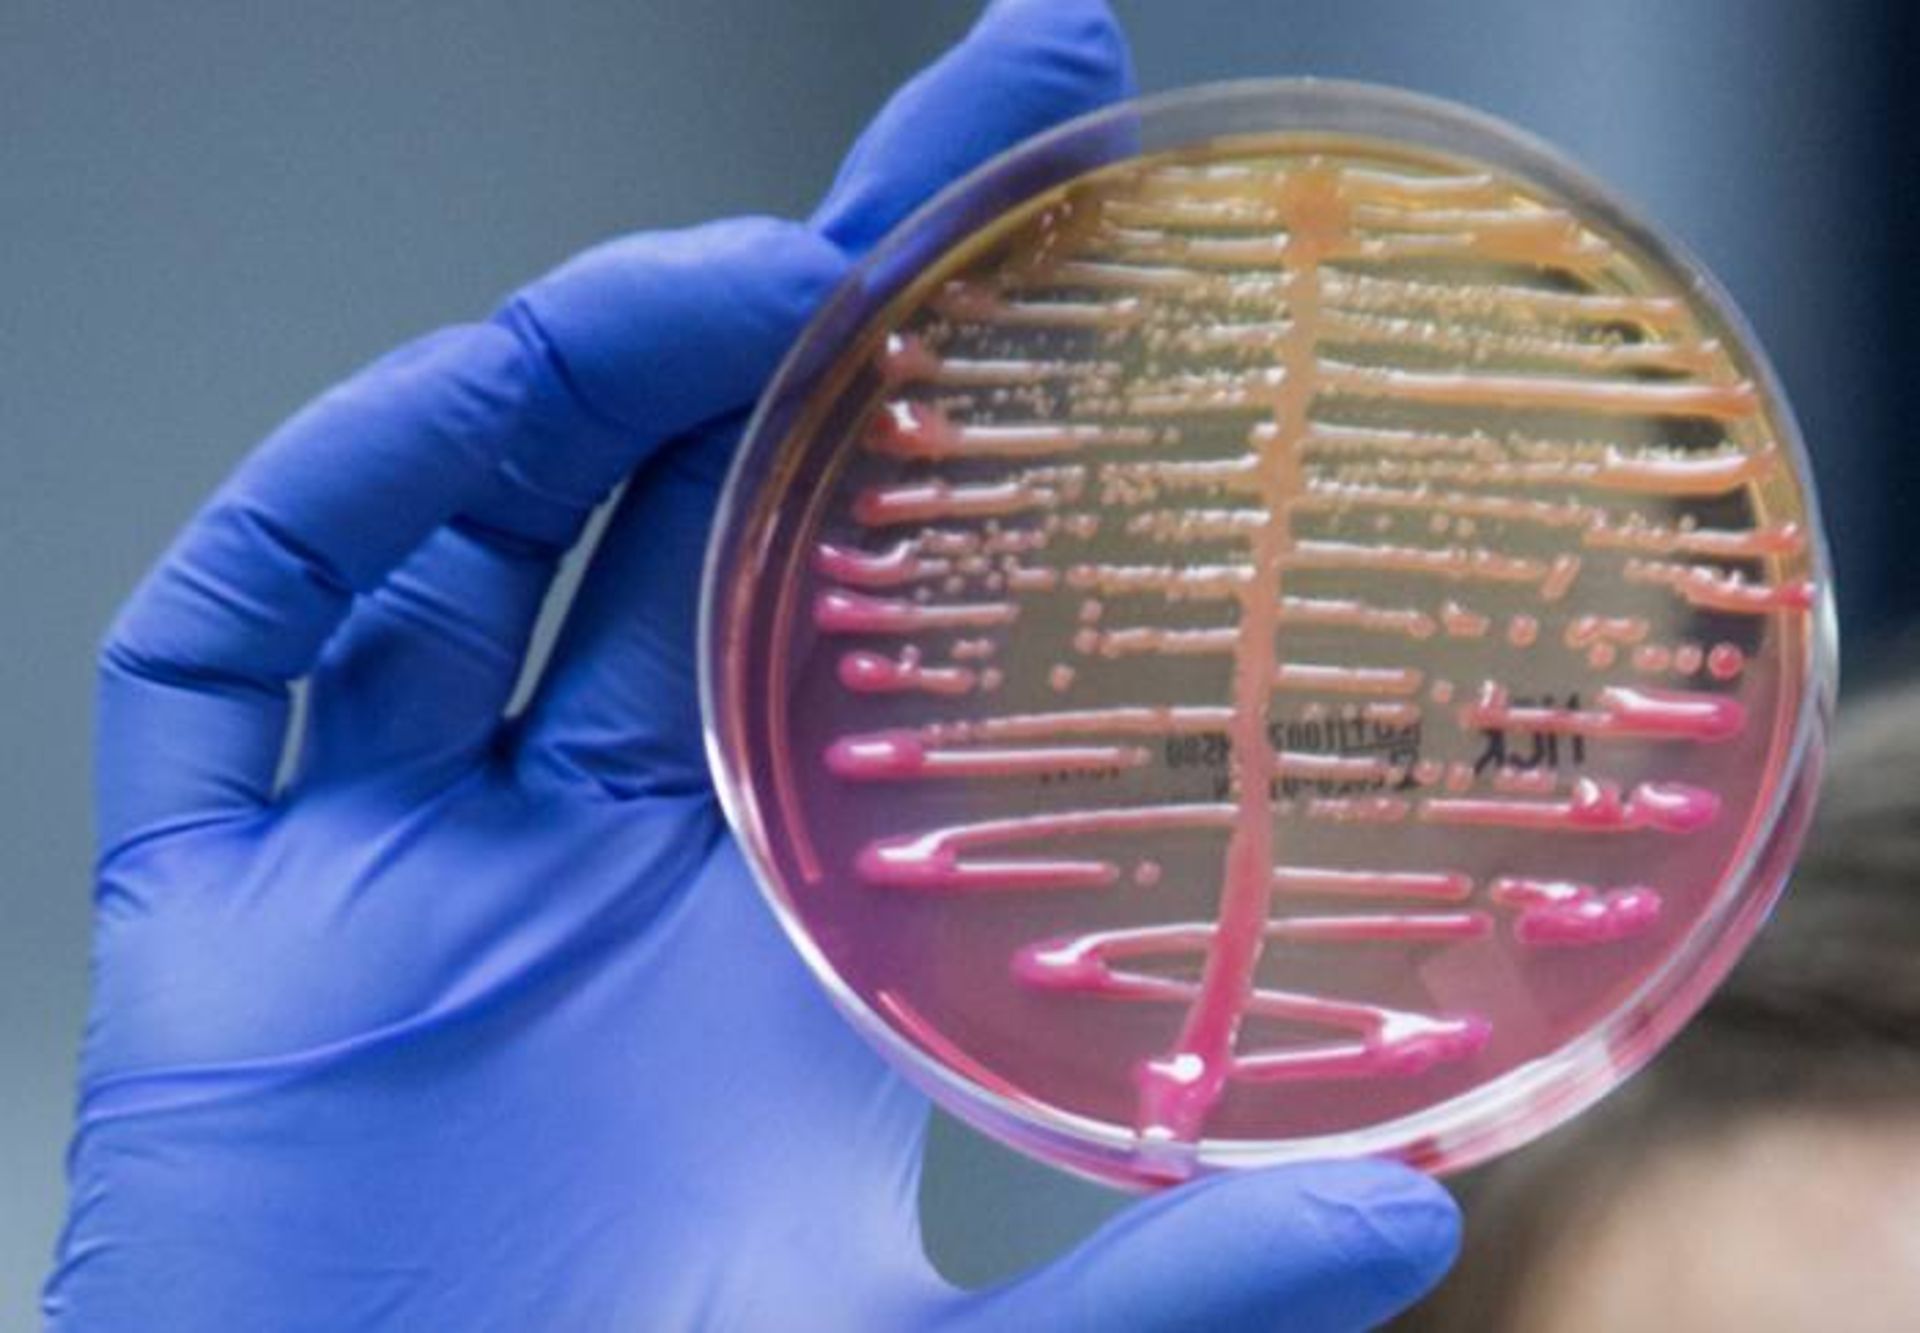
کشت کلبسیلا پنومونیه / Klebsiella pneumoniae

ویروسها درون زخم زنی بیمار رها شدند تا ابرمیکروب موجود در پای او را از بین ببرند

زخم دارای تراوش زنی بیمار پس از حدود دو سال درمان آنتیبیوتیکی که برای از بین بردن عفونت باکتریایی انجام میشد، بهبود پیدا نکرد. بنابراین، پزشکان ویروسهایی را برای از بین بردن این ابرمیکروب در زخم او آزاد کردند.
این درمان تجربی شامل ویروسهایی میشد که باکتریها را آلوده میکنند و «باکتریوفاژ» یا به اختصار «فاژ» نامیده میشوند. اگرچه آنتیبیوتیکها بهتنهایی نتوانسته بودند عفونت بیمار را درمان کنند، طبق گزارشی که ۱۸ ژانویه در مجلهی Nature Communications منتشر شد، ترکیبی از آنتیبیوتیکها و فاژدرمانی موفقیتآمیز بود.
دکتر آناییز اسکنازی، نویسنده نخست مطالعه و متخصص پزشکی داخلی و بیماریهای عفونی در بیمارستان CUB-Erasme در بروکسل بلژیک به لایوساینس گفت: «چند روز پس از درمان، زخم بیمار خشک شده بود و دیگر چرکی از آن خارج نمیشد و رنگ پوست از خاکستری به صورتی در حال تغییر بود.»
سه ماه پس از فاژدرمانی، پزشکان نشانهای از ابرمیکروب را در بیمار پیدا نکردند و زخم او در حال بهبودی بود. سه سال پس از درمان، عفونت باکتری عود نکرده است.
پل ترنر، استاد بومشناسی و زیستشناسی تکاملی در دانشگاه ییل که در مطالعه مشارکت نداشت، گفت: «این پژوهش را بهعنوان شاهد قانعکنندهای میبینم که نشان میدهد میتوان از همافزایی آنتیبیوتیک و فاژ استفاده کرد.» یعنی اینکه باکتریوفاژها و داروها با هم کار میکنند تا ابرمیکروب را بهطور موثرتری از بین ببرند. این نوع اثر همافزایی در مطالعات قبلی از جمله پژوهشهای خود ترنر نشان داده شده بود و گزارش موردی جدید شواهد بیشتری در این زمینه مهیا میکند که این اثر چگونه میتواند برای بیماران انسانی مفید باشد.
همافزایی فاژ-آنتیبیوتیک
بر اساس گزارشی که سال ۲۰۱۷ در مجلهی World Journal of Gastrointestinal Pharmacology and Therapeutics منتشر شد، مفهوم استفاده از ویروسها برای کشتن باکتریها برای اولینبار بیش از یک قرن پیش یعنی تقریباً یک دهه پیش از کشف پنیسیلین در سال ۱۹۲۸ ظاهر شد. اگرچه در آن زمان، درک دانشمندان از فاژها محدود بود و بهدنبال کشف و تولید آنتیبیوتیکها، این حوزه از علم تا حد زیادی رها شد.
بااینحال، گروههای پژوهشی مختلفی در اتحاد جماهیر شوروی سابق و اروپای شرقی به مطالعهی فاژدرمانی و انجام کارآزماییهای بالینی انسانی از این درمان با موفقیتهای متفاوت ادامه دادند.
علاقه به فاژدرمانی طی دهه گذشته وقتی دانشمندان شروع به جستوجوی استراتژیهای جدیدی برای غلبه بر ابرمیکروبهای مقاوم در برابر آنتیبیوتیک کردند، دوباره ظاهر شد.
بر اساس گزارشی که سال ۲۰۲۱ در مجلهی Proceedings of the National Academy of Sciences منتشر شد، یکی از مشکلات موجود این است که فاژدرمانی شکستناپذیر نیست. درست همانطور که باکتریها میتوانند تکامل پیدا کنند تا بر آنتیبیوتیکها غلبه کند، آنها همچنین میتوانند تکامل پیدا کنند تا در برابر فاژهای خاص مقاومت کسب کنند. بااینحال، تفاوت در اینجا است که فاژها به آسانی میتوانند تکامل پیدا کنند تا بر مقاومت ایجادشده در باکتریها غلبه کنند. علاوهبراین، درحالیکه باکتریها ژنهای مقاومت به آنتیبیوتیک را مبادله میکنند، بهراحتی قادر نیستند چنین کاری را در مورد ژنهای مقاومت در برابر فاژ انجام دهند.
دانشمندان با در نظر گرفتن این مسئله در حال مطالعه این موضوع هستند که چگونه میتوانند از انعطافپذیری ژنتیکی فاژها در مبارزه در برابر ابرمیکروبها استفاده کنند. مطالعهی موردی جدید مثالی از نحوهی آموزش دادن فاژها برای کشتن کارآمد باکتریهای خاص را طی فرایندی که «پیشسازگاری» نامیده میشود، ارائه میدهد.
بیمار مورد مطالعه پس از جراحی بزرگی روی ران چپ دچار عفونت نوعی ابرمیکروب شد. استخوان ران او در جریان بمبگذاری که مارس ۲۰۱۶ در فرودگاه بروکسل رخ داد، شکسته بود و پزشکان پس از مراقبت از جراحتهای وارده، برای تثبیت استخوان از پینها، پیچها و قاب تثبیتکننده استفاده کردند.
بهگزارش مرکز کنترل و پیشگیری بیماری، زخم جراحی زن پس از آن به باکتری کلبسیلا پنومونیه (نوعی باکتری که موجب عفونتهای مختلف مرتبط با مراقبتهای بهداشتی میشود) آلوده شد. بیماران هنگام استفاده از دستگاه تنفس مصنوعی، دریافت داروها از طریق وریدی یا مانند بیمار مورد مطالعه، هنگام عمل جراحی، ممکن است در معرض این میکروب قرار گیرند.
به گزارش مرکز کنترل و پیشگیری بیماری، بسیاری از باکتریهای کلبسیلا در برابر داروهای آنتیبیوتیک مقاوم شدهاند. در این مورد، نمونهبرداریها نشان داد بیمار حامل دو سویه از کلبسیلا پنومونیه است که یکی از آنها «فنوتیپ بسیار مقاوم به دارو» را نشان میداد.
بیمار طی سه ماه بستری در بیمارستان، تحت رژیمهای مختلف آنتیبیوتیک قرار گرفته بود اما شکستگی استخوان او ترمیم نشده بود و عفونت همچنان وجود داشت. در این مرحله، گروه پژوهشی به گزینهی فاژدرمانی فکر کردند.
کلبسیلا پنومونیه بهطور معمول موجب عفونت در محیطهای مراقبتهای بهداشتی میشود و اغلب در برابر آنتیبیوتیکها مقاوم است
اسکنازی گفت بیمار جدید کاندیدای خوبی برای فاژدرمانی بود، تا حدی به این علت که عفونت او با زیستلایه همراه بود. زیستلایهها زمانی تشکیل میشوند که کلنیهای باکتری به سطح میچسبند و ماتریکسی سهبعدی را تولید میکنند که همچون سد محافظی سلولهای آنها را فرامیگیرد.
داروهای آنتیبیوتیک برای نفوذ به این لایهها به مشکل برمیخورند و حتی زمانی که از آن عبور میکنند، برخی از سلولهای باکتریایی به حالت خفته درمیآیند و ازحمله آنتیبیوتیک در امان میمانند. آنتیبیوتیکها معمولاً ازطریق مختل کردن عملکرد سلول باکتریایی عمل میکنند و روی سلولهای خفته تأثیری ندارند.
اما حتی زمانی که آنتیبیوتیکها نمیتوانند باکتریهای قفلشده پشت زیستلایهها را تخریب کنند، فاژدرمانی ممکن است این ابرمیکروبها را نابود کند. اسکنازی گفت: «بسیاری از فاژها توانایی تخریب زیستلایه را دارند و بنابراین به آنتیبیوتیکها کمک میکنند تا راحتتر به اهدافشان برسند.»
گروه پزشکی برای شناسایی بهترین فاژ برای انجام این کار، نمونههایی از سویههای K. pneumoniae بیمار را گرفتند و آنها را به مؤسسهی تحقیقات جورج الیاوا در تفلیس گرجستان فرستادند که مؤسسهای غیرانتفاعی است که روی فاژها و کاربردهای بالقوهی آنها کار میکند.
پژوهشگران به کمک کتابخانهی بزرگ مؤسسه از باکتریوفاژها، فاژی را شناسایی کردند که بهطور کارآمد میتوانست سویههای K. pneumoniae بیمار را آلوده کرده و نابود کند. آنها سپس آن فاژ و سویههای باکتریایی را در ظرفهای آزمایشگاهی قرار دادند. این کار به فاژ اجازه داد تا باکتری را آلوده کند، نسخههایی از خود بسازد و حین انجام این کار، جهشهایی به دست آورد. با گذشت زمان، این جهشها به فاژ کمک کرد که بهطور کارآمدتر باکتری را بکشد. در پایان آزمایش، پژوهشگران فاژهای جهشیافته را بررسی کردند تا بهترین باکتریکُشها را شناسایی کنند و سپس این فرایند را با فاژهای بَرنده تکرار کردند. پس از ۱۵ بار تکرار این فرایند، آنها فاژ جهشیافتهای را تولید کردند که به اندازهی کافی قوی بود که بتواند با K. pneumonia بیمار مبارزه کند.
ترنر گفت این نوع تکامل هدایتشده که نویسندگان آن را پیشسازگاری مینامند، در مطالعات فاژدرمانی دیگر برای قویتر کردن باکتریوفاژ پیش از اینکه وارد نبرد با باکتری شود، مورد استفاده قرار گرفته است.
بیمار ابتدا برای دریافت این فاژدرمانی بهینه در نوامبر ۲۰۱۶ پس از اینکه کمیتهی اخلاقی بیمارستان مجوز انجام این رویه را داد، تأیید شد. بااینحال، به دلیل عدم توافق پزشکان معالج، درمان تا فوریه ۲۰۱۸ به تعویق افتاد. در آن زمان، ۷۰۲ روز از جراحات اولیهی بیمار گذشته بود و او مدت زمان زیادی آنتیبیوتیک مصرف میکرد.
بیمار سرانجام پس از رویهی جراحی تحت فاژدرمانی قرار گرفت. طی عمل جراحی، پزشکان بافت مرده و آسیبدیده را از زخم او جدا کردند و پیوندهای استخوانی را وارد کردند که با آنتیبیوتیکی آغشته بود و قابی را که به تثبیت استخوان شکسته او کمک میکرد، عوض کردند. در پایان این رویه، تیم کاتتری را وارد زخم کرد که از طریق آن میشد فاژهای پیشسازگارشده را وارد زخم کرد.
پزشکان کاتتر را به مدت ۶ روز در محل قرار دادند و هر روز فاژدرمانی را اجرا کردند، درحالیکه همچنان داروهای آنتیبیوتیک را به بیمار رساندند. بیمار طی دو روز از آغاز فاژدرمانی بهبودهایی را نشان داد، اما علاوهبرآن، درمان آنتیبیوتیک جدیدی را علیه K. pneumonia مقاوم به دارو دریافت کرد.
سه ماه بعد، بیمار عاری از عفونت بود و هم زخمها و استخوان ران او رو به بهبودی بودند. در این مرحله، پزشکان قاب تثبتکننده را از پای بیمار برداشتند و همه درمانهای آنتیبیوتیکی او را قطع کردند. بنا به گزارش نویسندگان، سه سال پس از درمان ترکیبی فاژ-آنتیبیوتیک، بیمار معمولاً به کمک عصا، توانایی حرکت و شرکت در رویدادهای ورزشی مانند دوچرخهسواری را پیدا کرد. همچنین، نشانهای از عود عفونت K. pneumoniae وجود ندارد.
ترنر گفت این مطالعهی موردی نشان میدهد ترکیب فاژدرمانی و آنتیبیوتیکها میتواند K. pneumonia مقاوم به دارو را بهطور کارآمدی درمان کند.
البته این مطالعهی موردی نمیتواند نشان دهد که چه مقدار از بهبود بیمار ناشی از فاژها و چه مقدار نتیجهی رژیم جدید آنتیبیوتیکی او بوده است. اما با توجه به این موضوع که پیش از تغییر آنتیبیوتیکها، مقداری بهبود دیده میشد و آنتیبیوتیکهای قبلی تأثیری روی او نداشتند، میتوان گفت فاژها اثر داشتهاند.
ترنر پیشبینی میکند که در آینده زمانی که استفاده از فاژدرمانی فراگیرتر شود، این رویکرد مانند مورد گزارششده، گاهیاوقات همراه با آنتیبیوتیکها استفاده خواهد شد، اگرچه میتواند بهتنهایی نیز مؤثر باشد. او گفت: «خصوصاً اگر بهدنبال باکتری مقاوم به همهی داروها باشید که به هیچ آنتیبیوتیکی پاسخ نمیدهد.»
ترنر گفت برای اینکه متوجه شویم که چگونه فاژدرمانی میتواند به بهترین شکل به کار رود، باید دادههای بیشتری را از کارآزمایهای بالینی بزرگ جمعآوری کنیم و نه اینکه فقط بر گزارشهای موردی تکیه کنیم. او گفت: «آینده فاژدرمانی مبتنیبر دادههای فراوان حاصل از کارآزماییهای بالینی است. این فقط استاندارد طلایی است و فاژها نیز باید همین استاندارد را داشته باشند.» چنین کارآزماییهای در حال انجام است.